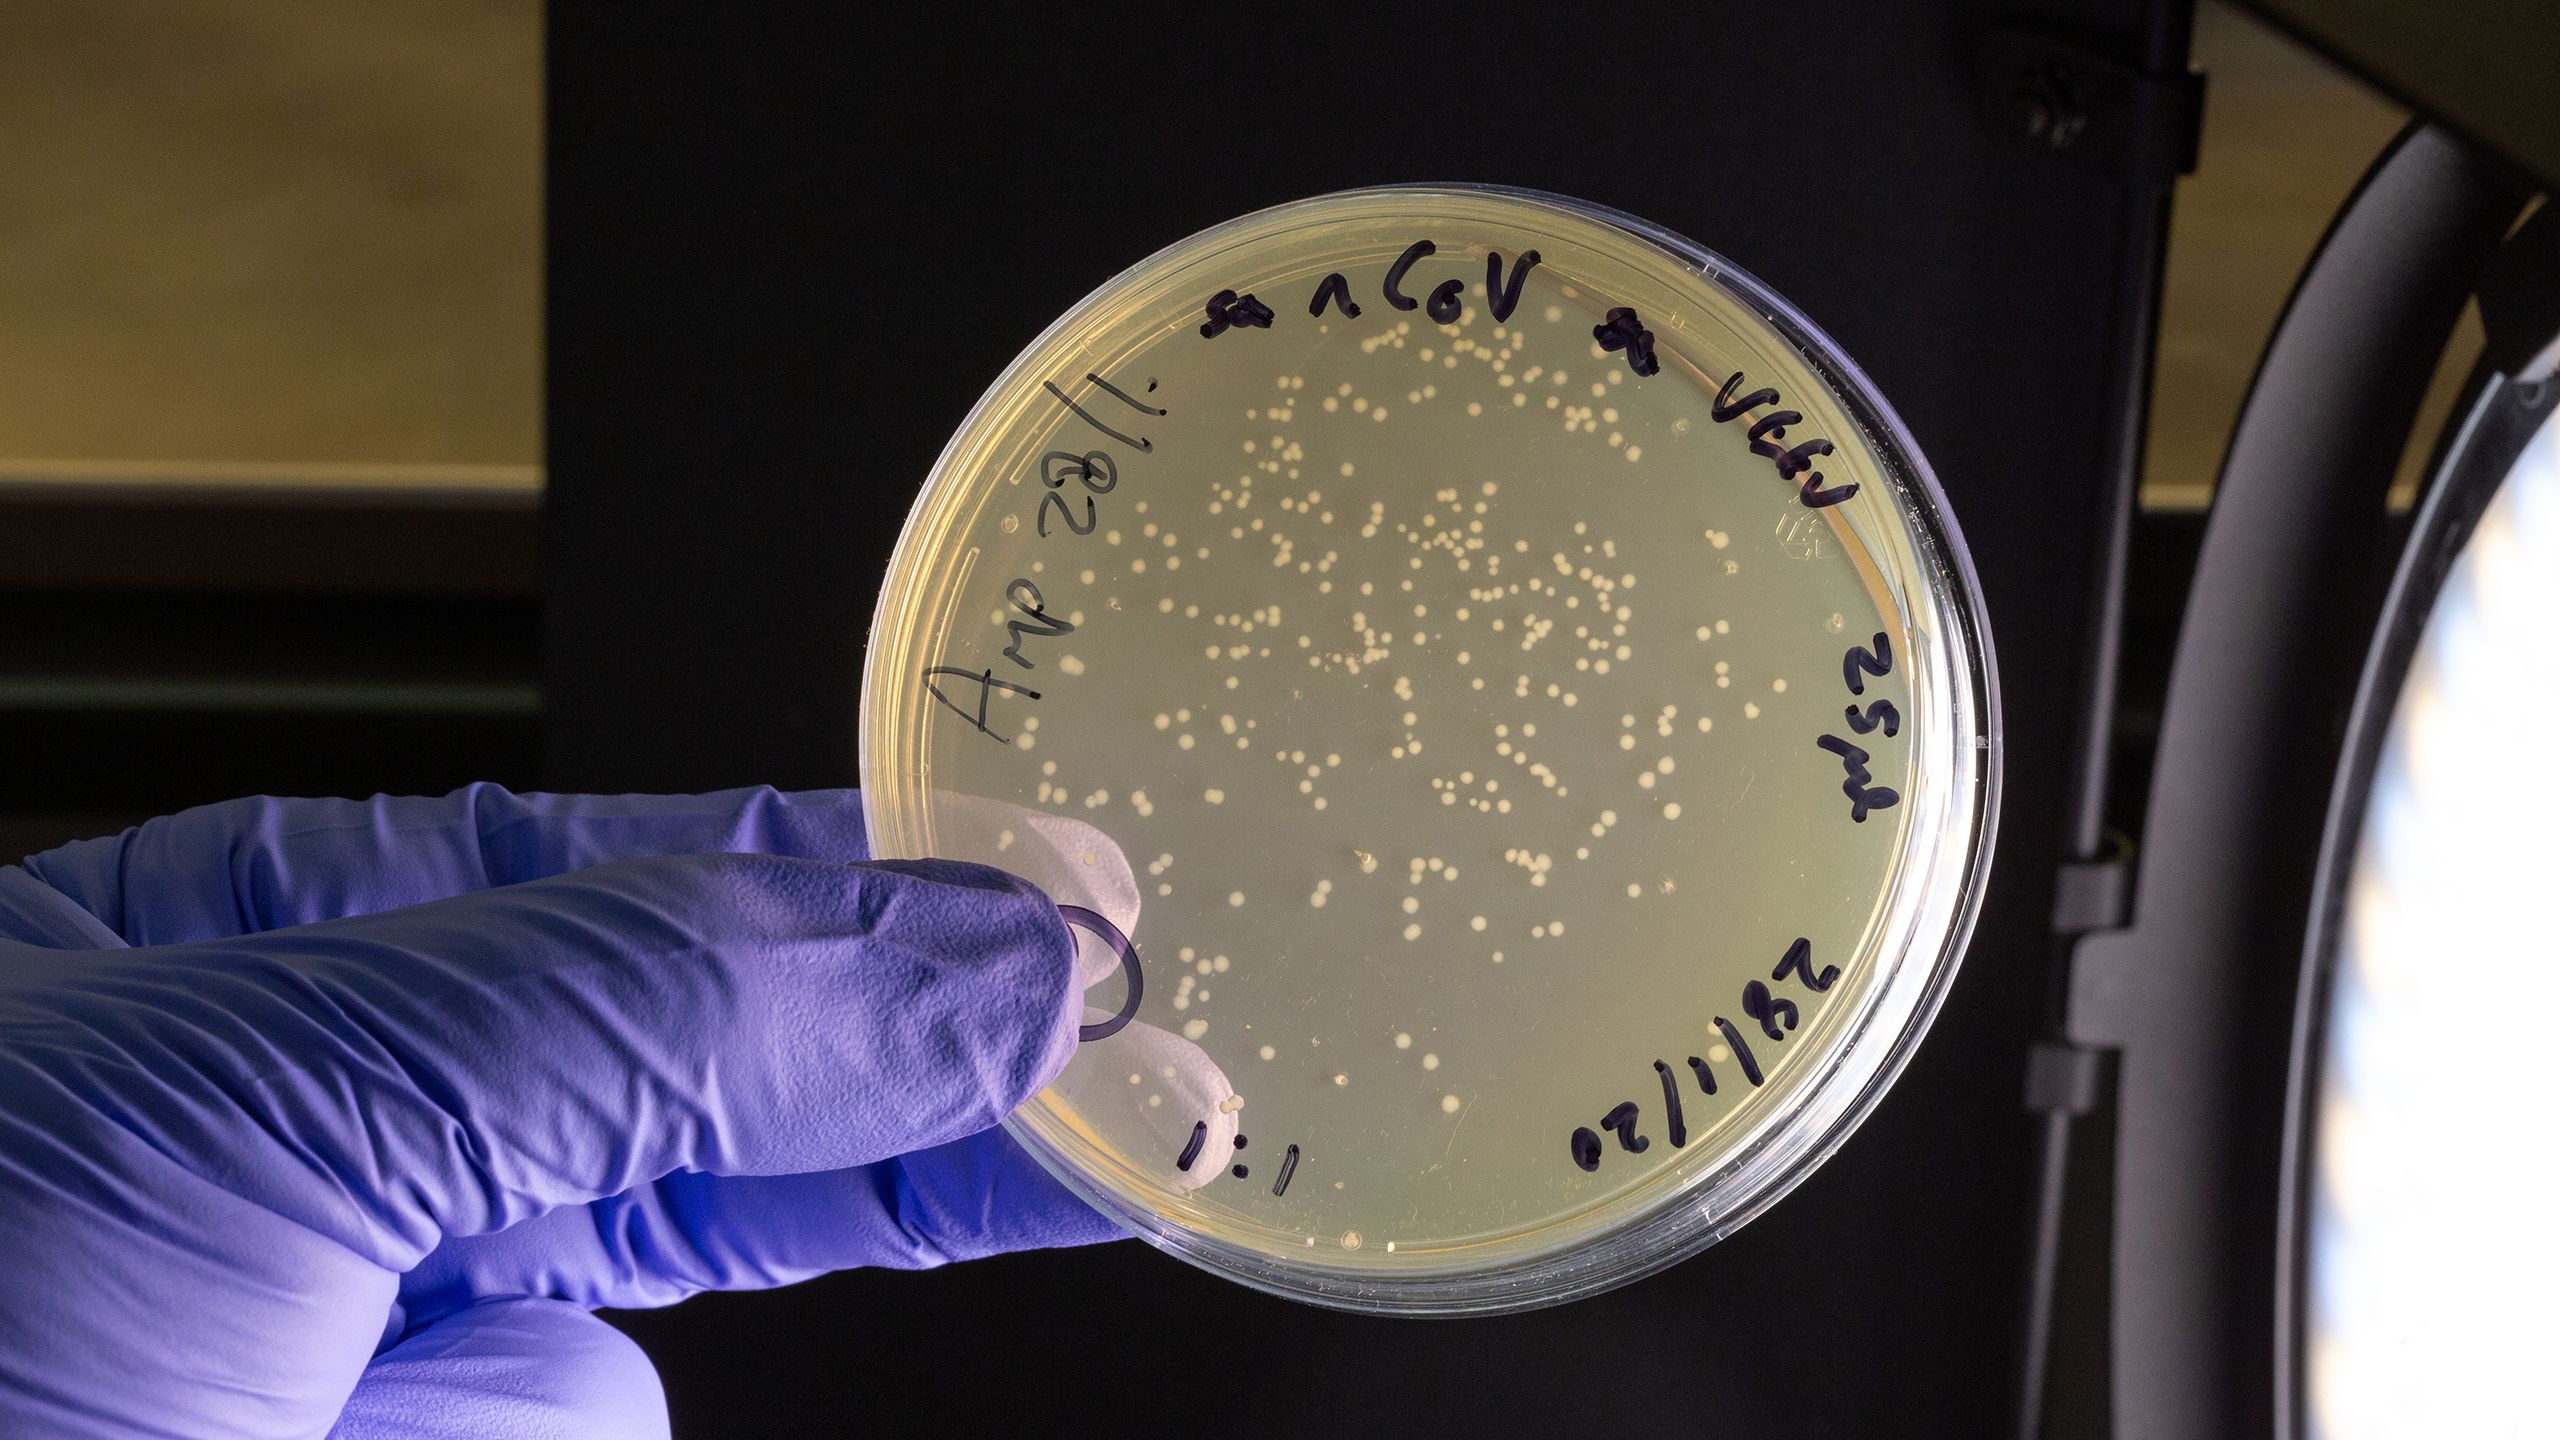

TOGETHER, WE CAN
Imperial's response to COVID-19 has put data and expertise in the hands of policy makers and governments around the world, informing decision making and saving lives.

From taking a vaccine from bench to bedside in a matter of months to epidemiological modelling that has saved thousands of lives, Imperial is at the frontline of the response to the COVID-19 pandemic. Its experts are influencing policy, driving innovation, keeping the public informed and working tirelessly, work that has been central to governments and healthcare services around the world as they respond to the pandemic .
Back in January, the common assumption was that the coronavirus threat was animal-to-human and could therefore be contained. But using data from airports and airlines, Imperial researchers were the first to show that human-to-human transmission was probably at work, and that the then unnamed coronavirus was likely to be deadly.
We’ve been providing public health decision-makers the best possible analysis of what threat a new disease causes
It was a vital insight, but no accident. Imperial had been getting ready for this new challenge for years. “All the way back to the 2003 SARS epidemic, through avian flu, the influenza pandemic of 2009, and Ebola and Zika, we’ve been providing public health decision-makers the best possible analysis of what threat a new disease causes,” says Professor Neil Ferguson of Imperial’s School of Public Health .
In 2018, the World Health Organization published its blueprint for research on priority diseases. Alongside the likes of Zika, SARS and Rift Valley fever, the WHO added a new threat – Disease X, a pathogen, still yet to emerge, that could cause the next human pandemic. In December 2018, Imperial and the Coalition for Epidemic Preparedness Innovations (CEPI) formed a partnership to protect against Disease X.
Then, in late 2019, the Abdul Latif Jameel Institute for Disease and Emergency Analytics (J-IDEA) was set up to bring together the College’s rapid response to emergencies such as pandemics, extreme climate events and natural and humanitarian disasters.
The epidemiological response was led by Professor Ferguson and other world-leading researchers such as Nick Grassly, Timothy Hallett, Katharina Hauck, Christl Donnelly, Azra Ghani and Steven Riley from the Jameel Institute and Imperial’s MRC Centre for Global Infectious Disease Analysis (MRC GIDA).
Throughout, Imperial researchers have sought to bring expertise and data to bear, sharing their research and methodologies in order to maximise the global response. Nowhere has that been more powerful than in the expert modelling – opened up by the College for scrutiny from some of the world’s leading coders – that has helped to provide vital data and projections to scores of governments and policy makers around the world. “The Imperial model, as we've been following this for weeks, was the best, most accurate model,” said Andrew Cuomo, Governor of New York State – one of the many governments around the world to use Imperial modelling to inform their response.
Professor Robin Shattock heads one of the few labs in the world developing a coronavirus vaccine.
Professor Robin Shattock heads one of the few labs in the world developing a coronavirus vaccine.
Early findings showed that animals given the vaccine can produce neutralising antibodies against SARS-CoV-2.
Early findings showed that animals given the vaccine can produce neutralising antibodies against SARS-CoV-2.
Professor Robin Shattock's team developed a candidate vaccine within 14 days of getting the genetic sequence of the virus.
Professor Robin Shattock's team developed a candidate vaccine within 14 days of getting the genetic sequence of the virus.
The first healthy volunteer received a candidate coronavirus vaccine in June 2020.
The first healthy volunteer received a candidate coronavirus vaccine in June 2020.
The Imperial vaccine trials are the first test of self-amplifying RNA (saRNA) technology, which has the potential to revolutionise vaccine development.
The Imperial vaccine trials are the first test of self-amplifying RNA (saRNA) technology, which has the potential to revolutionise vaccine development.
Now, as the world adjusts to a new normal, it is the vaccine work of Professor Robin Shattock that is in the spotlight. Over the past few years, Professor Shattock and his team of Imperial virologists have been steadily advancing a new concept in vaccine technology: a self-amplifying RNA vaccine. When COVID-19 emerged, they swiftly obtained its genetic code from China and, within 14 days, had a candidate vaccine to test on animals and prepare for human trials.
This astonishing speed is possible in part due to the revolutionary nature of the RNA vaccine technology developed at Imperial, where new genetic code, carrying an instruction to make, in this case, a protein found on the surface of coronavirus, is injected into the subject. “Your muscle becomes the factory that makes the vaccine that triggers your immune system to make protective white cells and antibodies,” says Professor Shattock. Early findings have shown that animals given the vaccine are able to produce neutralising antibodies against the novel coronavirus SARS-CoV-2, the virus strain that causes COVID-19.
The team is currently developing the vaccine further to include human safety trials. While the UK government has provided more than £40m in total to fast-track this vaccine development, donations of more than £4m have been raised for Professor Shattock’s vaccine work – with a further £29m in philanthropy required to carry out international clinical trials to enable widespread deployment of the vaccine by 2021. Meeting this timeline would break all records. However, with additional dedicated funding, it is achievable.
“We are working as fast as we can to determine the vaccine’s efficacy and to get to a position where millions or billions of the vaccine can be manufactured rapidly,” says Professor Shattock. “We are tremendously grateful to the UK government, the British people for their investment in this vital work. We are also thankful for the philanthropic support to the College itself that has helped us navigate funding blockages and which we hope will allow us to make this vaccine available worldwide, including to people in low- and middle-income countries.”
While work continues on a vaccine, testing is critical to tracking the virus, understanding its epidemiology, informing how patients are treated, and to suppressing transmission. And here, too, Imperial’s expertise is being harnessed across medical diagnostics, silicon-chip technology and materials science to deliver COVID-19 testing that can be affordably mass-produced and administered effectively at scale.
Coronavirus vaccine race
Stage one
Within weeks of the first cases of COVID-19, scientists in China sequenced and shared the genetic code of the SARS-CoV-2 virus.
Stage two
The Imperial team used this code to produce strands of DNA in the lab – these hold the building instructions for ‘spike’ proteins on the outside of the virus. The DNA is built into loops of genetic material (called plasmids) to produce copies of the self-amplifying RNA.
Stage three
The final vaccine is delivered as RNA strands in lipid droplets. To check if the vaccine is safe and effective, the team first needs to see if it produces an immune response in animals.
Stage four
The vaccine can ‘amplify’ itself inside the body, meaning it makes copies of the instructions it contains (in the form of RNA). Once injected into muscle, the cells should produce copies of the coronavirus protein, which will be picked up by the body's immune system as a threat.
Stage five
When immune cells come across these proteins, they will react by creating antibodies to fight off the danger. But they also create a lasting memory of the threat for any future attack.
Stage six
The hope is that the vaccine will train people's immune systems to recognise and defend against SARS-CoV-2. If they come into contact with the virus in future, they should be ready to fight it off, giving them some protection against COVID-19.
Stage seven
Having an effective vaccine would enable us to protect the frontline health workers who are dealing with patients. But it could also be extended to the general population.
Professor Christofer Toumazou, founder and chief scientist for the Institute of Biomedical Engineering, is pioneering work that can deliver COVID-19 test results in just over an hour without the need for a laboratory. It’s based on technology developed by Professor Toumazou for DnaNudge, an Imperial spinout that enables on-the-spot genetic test to be carried out for the first time, using a sample from a cheek swab. The technology has already been shown to be effective in early trials and is now entering larger trials with COVID-19 patients, with the ultimate view to roll out across the UK.
Understanding how the virus spreads will be crucial to its future management. COVID-19 is very likely to have jumped to humans from bats, though it’s not clear if it then found its way into another animal with close human contact and crossed the species that way. How can the risk of animal-to-human virus transmission be minimised? Professor Wendy Barclay, Head of the Department of Infectious Disease, is working on ways to prevent novel viruses from ever reaching humans at all.
Her fundamental research into influenza and how it spreads is likely to prove crucial to understanding how COVID-19 spreads – and how to stop it. Because of their simplicity, viruses need to use a raft of resources from the host cell in order to replicate. In 2016, Professor Barclay discovered the identity of one of these key resources. “It turned out that this protein is absolutely essential for influenza virus and, if you generate cells in the lab that don’t make this protein, they can’t be infected with influenza any more,” she explains.
Professor Wendy Barclay, Action Medical Research Chair in Virology, pioneers work into how respiratory viruses spread.
Professor Wendy Barclay, Action Medical Research Chair in Virology, pioneers work into how respiratory viruses spread.
Dr David Miller, Project Lead Support, was just one of many Imperial volunteers who made more than 50,000 disposable visors for Imperial College Healthcare NHS Trust hospitals.
Dr David Miller, Project Lead Support, was just one of many Imperial volunteers who made more than 50,000 disposable visors for Imperial College Healthcare NHS Trust hospitals.
The finger-prick antibody test being developed by Professor Ara Darzi.
The finger-prick antibody test being developed by Professor Ara Darzi.
The new test helps to improve understanding of virus infection rates and will inform future action to manage its spread.
The new test helps to improve understanding of virus infection rates and will inform future action to manage its spread.
Then there are basic questions to be answered about how the virus actually behaves: who is most at risk? Why? What’s the best way to diagnose it? What’s the best way to treat it? What role does the immune system have in protection – and in potentially causing harm?
“This pandemic has highlighted a number of crucial questions for which researchers, healthcare professionals and, crucially, the public and patients, need answers,” says Peter Openshaw, Professor of Experimental Medicine at the National Heart and Lung Institute. He’s one of three national co-leads on the International Severe Acute Respiratory Infection Consortium study (ISARIC 4C) funded by the MRC.
We hope our work will underpin a huge range of research going on in the UK
Professor Openshaw and his team are working with colleagues to collect clinical data and samples from more than 15,000 patients with COVID-19 admitted to 166 hospitals throughout the UK. Some of these samples have already been analysed by scientists at Imperial. “We hope our work will underpin a huge range of research going on in the UK and provide a clearer picture of the illness and its risk factors,” says Professor Openshaw.
And there is vital work being done outside the lab, too, combating the flood of misinformation and fake news that has spread along with the virus. Imperial researchers have partnered with the online learning platform Coursera to offer a free online course, Science Matters: Let’s talk about COVID-19.
Now more than ever we need to understand the science underpinning the response
Currently the most popular course launched on Coursera in 2020, it’s attracted 68,000 learners and 1.2 million page views so far. It features experts from the Jameel Institute explaining the theory behind the analyses of COVID-19 and its spread, and how to interpret new information using core principles of public health, epidemiology, medicine, health economics and social science. New content is being developed in real time as more information becomes available.
“Lockdown restrictions are having a dramatic impact on all aspects of life, and now more than ever we need to understand the science underpinning the response,” says the Jameel Institute’s Professor Helen Ward, Director of Education at the School of Public Health.
“In this rapidly changing world, the Imperial School of Public Health is doing its utmost to study the pandemic in real time in order to inform policy, and through this online course we are also sharing our learning and methods with tens of thousands of people across the globe.”
Imperial's critical work has been propelled forward by a combination of public funding and philanthropy. Hundreds of alumni, friends and staff have come together to provide rapid support for projects across the College through the Imperial College COVID-19 Response Fund and with specific funding for vaccine development and diagnostics.
Imperial is the magazine for the Imperial community. It delivers expert comment, insight and context from – and on – the College’s engineers, mathematicians, scientists, medics, coders and leaders, as well as stories about student life and alumni experiences.
This story was published originally in Imperial 48/Summer 2020.